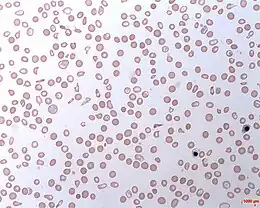
Description de l'image Haemolytic Anaemia.jpg.

Hémoglobinurie paroxystique nocturne
| Médicament | Éculizumab |
|---|---|
| Spécialité | Hématologie |
| CIM-10 | D59.5 |
|---|---|
| CIM-9 | 283.2 |
| OMIM | 300818 |
| DiseasesDB | 9688 |
| MedlinePlus | 000534 |
| eMedicine | 207468 |
| MeSH | D006457 |
![]() Mise en garde médicale
Mise en garde médicale
L'hémoglobinurie paroxystique nocturne (HPN) , aussi appelée maladie de « Marchiafava et Michelli » est une cause rare d'anémie.
Épidémiologie
L'HPN est une maladie identifiée un peu avant la Seconde Guerre mondiale. À ce jour, on en a diagnostiqué à peine 500 cas en France.
Physiopathologie
Cette affection est causée par une mutation du gène PIG-A[1], impliqué dans la synthèse de Phosphatidyl-Inositol Glycane (PIG). Le PIG (et son dérivé le GPI) est lui-même nécessaire à l'ancrage membranaire de plusieurs protéines de membrane des cellules sanguines[2], en particulier le CD59 ou Protectine et le CD55 ou Decay Accelerating Factor (DAF). CD55 et CD59 sont deux protéines de surface des hématies et des monocytes qui inhibent la constitution du complexe d'attaque membranaire du complément[3]. Le déficit en PIG provoque donc une perte d'ancrage membranaire de CD55 et CD59, donc un défaut de protection de la membrane des hématies contre la lyse par le complément.
Les thrombocytes sont également déficientes en CD59, les rendant plus sensibles à l'action du système du complément, ce qui peut expliquer les phénomènes thrombotiques[4].
Le complément étant plus actif en milieu acide, donc en deuxième moitié de nuit (le pH sanguin est alors plus bas), l'hémolyse (lyse des hématies) se produit donc de façon plus importante durant la nuit.
Historique
C’est à la fin du XIXe siècle que Gull puis Strübing décrivent le cas de patients présentant une hémoglobinurie intermittente accompagnée d’hémolyse intravasculaire[5]. Marchiafava et Nazari en 1911, puis Micheli en 1931, établissent le tableau clinique classique de la maladie.
L’hémoglobinurie paroxystique nocturne (HPN), ou maladie de Marchiafava & Micheli, est aujourd’hui considérée comme une maladie de la cellule souche hématopoïétique. Depuis le début des années 1980 les progrès de la cytométrie en flux puis, plus récemment, de la biologie moléculaire ont conduit à une réelle avancée dans la connaissance de la physiopathologie de cette maladie rare.
Dès les premières descriptions de la maladie, au début du siècle, la sensibilité anormale des globules rouges à l’action lytique de complément (protéines du système immunitaire) a été considérée comme la caractéristique princeps de la maladie.
Au début des années 1980, plusieurs équipes ont démontré que 2 protéines, dont le rôle est d’inhiber l’action du complément, n’étaient pas exprimées à la surface des globules rouges de patients atteints d’HPN. Ces 2 molécules sont le DAF (decay accelerating factor) ou CD55 et le MIRL (membrane inhibitor of reactive lysis) ou CD59.
À la suite de ces travaux montrant le défaut d’expression du CD55 et du CD59 d’autres déficits moléculaires ont été identifiés sur les cellules de patients atteints d’HPN. Toutes ces molécules ont un élément structurel commun : elles sont attachées à la membrane par une ancre glycosyl-phosphatidylinositol (GPI).
Alors même que les protéines qui sont exprimées physiologiquement à la membrane des cellules sanguines sont normalement synthétisées, elles ne sont donc pas exprimées dans l’HPN par défaut de synthèse de leur système d’ancrage GPI.
Récemment, une étape fondamentale dans la compréhension de la maladie a été franchie grâce au groupe du Dr Kinoshita qui a démontré que l’HPN était liée à des anomalies d’un gène nommé PIG-A. Le gène PIG-A est situé sur le chromosome X.
Ces découvertes fondamentales ont ouvert la voie d’études moléculaires de l’HPN. Plusieurs équipes ont démontré que des altérations moléculaires du gène PIG-A sont retrouvées chez tous les patients atteints d’HPN à ce jour.
Mais, point important, les mutations décelées à ce jour, se situent sur l’ensemble du gène. Il n’existe donc pas de « point chaud » de mutation dans PIG-A. Ainsi, malgré le fait que de telles études sont indispensables pour l’extension de nos connaissances sur le plan fondamental, il semble illusoire à ce jour de croire au développement d’un diagnostic moléculaire en pratique clinique.
L’ensemble des travaux conduit depuis de nombreuses années dans cette maladie ont conduit Rotoli et Luzzatto à proposer un modèle dans lequel la population médullaire GPI- (issue d’une ou quelques cellules souches) possède un avantage de croissance (ou de survie) intrinsèque face à un mécanisme d’agression responsable d’une aplasie médullaire
Symptômes
Les signes sont très variables et la maladie peut rester silencieuse longtemps[6].
La forme la plus classique, sinon la plus courante, de la maladie est celle d’une anémie hémolytique acquise, apparaissant chez un adulte jeune, accompagnée d’urines foncées le matin et parfois d’un ictère modéré. L’anémie est accompagnée d’un signe de régénération modéré (réticulocytose) et souvent d’un certain degré d’insuffisance médullaire.
Au diagnostic, dans la série de la Société Française d’Hématologie (SFH), la moyenne d’âge était 33 ans mais près de 15 % des patients étaient des enfants (moins de 16 ans). Seul un tiers des patients avait une anémie isolée et un tiers des patients se présentait initialement avec une pancytopénie, généralement modérée.
Le problème majeur qui vient grever l’évolution des patients atteints d’HPN sont les thromboses (qui peuvent être inaugurales). L’incidence des thromboses dans la série de la SFH est de 25 % à 5 ans. Les deux localisations les plus fréquentes de ces thromboses sont les veines sus-hépatiques (syndrome de Budd-Chiari) et le système nerveux central.
Deux autres complications sont aussi fréquemment rencontrées (chacune chez 20 % des malades) : des crises douloureuses abdominales (de mécanisme incertain : microthromboses mésentériques, dystonie musculaire lisse par chélation du NO via l'hémoglobine libre) et des infections récurrentes.
Le maître symptôme est l'hémoglobinurie matinale (présence dans les premières urines du matin de l'hémoglobine libérée des hématies, lorsque celles-ci ont éclaté durant la nuit). Ainsi, les urines du matin ont une couleur brun-rouge comparable à la couleur du Coca-Cola ou du porto.
Ceci s'accompagne de douleurs lombaires, en regard des reins, qui peuvent être intenses, surtout en début de journée.
Et bien sûr, il y a tous les signes classiques de l'anémie chronique (le diagnostic est souvent fait au bout de quelques mois seulement) :
- fatigue
- faiblesse musculaire
- essoufflement au moindre effort
- pâleur cutanéo-conjonctivale
- céphalées, acouphènes
- souffle cardiaque fonctionnel méso-systolique à l'auscultation
L'hémoglobinurie paroxystique nocturne (HPN) doit être évoquée en cas de :
- urines rouges attribuées à une hémoglobinurie (cette hémoglobinurie est souvent intermittente et à prédominance nocturne mais ce caractère est inconstant) ;
- anémie hémolytique (évoluant par poussées) à test de Coombs négatif, sans anomalie morphologique des globules rouges sur le frottis sanguin (et sans déficit en G6PD chez un patient originaire d'une zone où cette anomalie génétique est fréquente) ;
- maladie thrombotique artérielle (en particulier cérébrale ou pulmonaire, avec hypertension artérielle pulmonaire[7]) ou veineuse (en particulier mésentérique ou en cas de syndrome de Budd-Chiari). L'association maladie hémolytique - maladie thrombotique doit faire évoquer le diagnostic ;
- aplasie médullaire idiopathique voire myélodysplasie (une étude montre que des cellules caractéristiques de I'HPN sont retrouvées dans 22 % des cas d'aplasie médullaire idiopathique et 23 % des cas de myélodysplasie[8].
L'anémie hémolytique de l'HPN peut n'être pas régénérative en cas de carence martiale liée à l'hémosidérinurie.
La leuconeutropénie est associée dans la moitié des cas. La thrombopénie est observée dans 80 % des cas mais reste généralement modérée.
En pratique courante, l'HPN est diagnostiquée dans deux circonstances :
- la maladie hémolytique et thrombosante classique que l'on peut appeler l'HPN "primitive" ou "de novo" ;
- la découverte d'un clone HPN chez un patient atteint d'aplasie médullaire traité quelques mois ou années auparavant par immunosuppression (sérum antilymphocytaire et/ou ciclosporine). La mise en évidence d'une telle complication après un traitement immunosuppresseur des aplasies médullaires est de plus en plus fréquente, en particulier grâce à l'utilisation récente de la cytométrie en flux comme outil diagnostique.
Évolution
Il existe des risques de transformation en leucémie aiguë au bout de quelques années. Il peut par ailleurs se produire une sidération médullaire[7], c'est-à-dire un blocage de l'hématopoïèse dans la moëlle osseuse, de mécanisme inconnu, mais probablement liée à l'hémolyse intra-médullaire qui accompagne l'hémolyse intra-vasculaire sus-décrite, les cellules hématopoïétiques portant elles aussi du CD 55 et du CD 59.
Il peut exister des rémissions spontanées prolongées[9].
La grossesse des femmes atteintes de cette maladie s'accompagne fréquemment d'une maladie thrombo-embolique potentiellement grave[10].
Elle peut être responsable d'infections à répétition[7].
Avant l'apparition du traitement par l'éculizumab, la survie moyenne était d'une dizaine d'années après le diagnostic[9].
Bilan biologique
En premier lieu, l'hémogramme pose le diagnostic d'anémie macrocytaire. On fera aussi un comptage des réticulocytes (comme pour toute anémie).
Ensuite, il faut prouver que l'anémie est bien de cause hémolytique, en dosant dans le sang, la bilirubine totale et la bilirubine libre, la LDH, l'haptoglobine (qui est effondrée),
Dans une troisième étape, il faut éliminer les causes d'anémie hémolytique autres que l'HPN : parasitoses par des tests sérologiques et un frottis sur couche mince ou goutte épaisse, bactériémies (dont Clostridium perfringens) par des hémocultures, l'hypersplénisme par analyse de la durée de vie des globules rouges au technétium 99m, une cause auto-immune par test de Coombs direct, une cause mécanique, une hémoglobinopathie par électrophorèse de l'hémoglobine, une enzymopathie par dosage de la G6PD et de la pyruvate kinase, une cytosquelettopathie par analyse de la déformabilité des hématies et une myélodysplasie par ponction-biopsie de la moelle osseuse
Enfin, si toutes ces causes sont éliminées, on recherchait une HPN par des 'tests de résistance à l'hémolyse : test au saccharose, test en milieu acide, test au chlorure de sodium. Aujourd'hui, ces tests ne sont presque plus pratiqués. Ils sont remplacés par l'analyse moléculaire par cytométrie en flux de CD55 et de CD59.
Diagnostic immunocytologique
Le test Ham-Dacie est basé sur l'acidification du sérum et était historiquement l'un des premiers tests pour le diagnostic de la maladie.
Bien que les molécules GPI liées puissent être étudiées dans des extraits cellulaires par méthodes radio-immunologique ou par ELISA, l'outil le plus performant est l'étude immunocytologique par cytométrie en flux. Cette technique permet l'analyse rapide des différentes populations leucocytaires à partir de sang total. Les résultats obtenus peuvent être exprimés en pourcentage de cellules négatives (importance relative du clone) et/ou en moyenne d'intensité de fluorescence (unité arbitraire en échelle logarithmique). Cette dernière manière est utile d'une part, pour l'étude de certaines molécules comme le CD16 ou le CD58 dont l'expression physiologique est faible, d'autre part, dans la mise en évidence de populations dites « intermédiaires » ou PNH II (population cellulaires exprimant à leur surface un niveau faible, mais non nul d'une molécule GPI donnée). La sensibilité de la cytométrie en flux dans le diagnostic d'un déficit des molécules GPI permet de détecter des clones (populations anormales) dont l'importance n'excède pas quelques pour cent. En pratique pour la majorité des molécules étudiées, un déficit peut être considéré comme significatif lorsque le pourcentage de cellules négatives est supérieur à 5 %.
L'ensemble des auteurs s'accordent pour dire que la cytométrie en flux est une méthode plus sensible et spécifique que les tests classiques[11]. D'autre part, si, dans le diagnostic des formes de novo, les résultats des tests classiques sont dans l'immense majorité des cas, tout à fait concordants avec ceux de la cytométrie en flux.
Traitement des symptômes
La rareté de cette maladie rend difficilement évaluable les bénéfices des thérapeutiques utilisées. Certains grands traits se dégagent tout de même.
En cas d'anémie sévère ou mal tolérée, les concentrés globulaires demeurent indispensables. Hormis les transfusions, certains patients peuvent bénéficier de supplémentation en fer pour compenser une perte urinaire journalière de 20 mg de fer sous forme d'hémosidérine. Mais la prise de fer peut provoquer des douleurs abdominales. Il est également d'usage de supplémenter en acide folique (vitamines B9) tous les patients présentant une anémie hémolytique chronique du fait de l'hyper production médullaire compensatrice. Le GCSF peut être prescrit dans les formes aplasiques, avec des résultats mitigés. Certaines équipes médicales ont essayé l'érythropoïétine (EPO) qui peut aider à limiter les transfusions.
Les immunosuppresseurs sont potentiellement utiles. En effet la ciclosporine, et le sérum anti-lymphocytaire ont été employés avec succès dans certaines formes très pancytopéniques (numération formule sanguine basse).
Les androgènes semblent avoir une certaine efficacité bien que leur mécanisme d'action ne soit pas très bien connu.
Les corticoïdes aussi sont parfois efficaces. Ils auraient un intérêt dans les formes hémolytiques mais n'auraient pas d'effet sur hématopoïèse. Un traitement de six semaines inefficace doit être interrompu ;
L'utilisation d'anticoagulants est prônée en cas de précédent de thrombose.
En cas de douleurs abdominales, maux de tête provoqués par les crises hémolytiques, sont prescrits des antalgiques plus ou moins puissants. Certains patients se plaignent également de spasmes œsophagiens, leur cause reste encore mal connue mais il semble que la présence l'hémoglobine libérée dans le sang réduise les concentrations efficaces locales d'acide nitrique connu pour relaxer les fibres musculaires lisses. En cas de nausées souvent est préconisée la prescription d'antinauséeux.
Les infections sont souvent récurrentes (sphère ORL et pulmonaire) et traitées par antibiotiques.
La greffe de moelle osseuse reste la seule thérapeutique curative mais elle est grevée d'une lourde mortalité et le plus souvent réalisée à partir d'un donneur de la fratrie. Elle est réservée aux formes avec aplasie ou aux patients non éligibles à un traitement par l'éculizumab. Elle ne semble pas améliorer les formes essentiellement thrombotiques[12].
L'éculizumab, anticorps monoclonal se liant à la molécule du complément C5, a montré son efficacité en diminuant l'hémolyse, le risque de thrombose et en améliorant la qualité de vie et le pronostic[13], dont la mortalité[14]. Il persiste, dans certains cas, une hémolyse qui reste moindre que spontanément, probablement extravasculaire[15]. Il est commercialisé par le laboratoire Alexion sous le nom de Soliris. C'est le médicament le plus cher au monde : 34,125 dollars par mois de traitement. Le ravulizumab a une efficacité comparable à celle de l'éculizumab, tout en nécessitant des injections moins fréquentes[16].
Le pegcetacoplan est un inhibiteur de la fraction C3 du complément et semble supérieur à l'éculizumab pour la maîtrise de l'hémolyse[17]. L'iptacopan cible le facteur B du complément et semble supérieur aux médicaments ciblant la molécule C5 du complément[18].
Notes et références
- ↑ Bessler M, Mason PJ, Hillmen P et al. Paroxysmal nocturnal haemoglobinuria (PNH) is caused by somatic mutations in the PIG-A gene, EMBO J, 1994;13:110-117
- ↑ Takeda J, Miyata T, Kawagoe K et al. Deficiency of the GPI anchor caused by a somatic mutation of the PIG-A gene in paroxysmal nocturnal hemoglobinuria, Cell, 1993;73:703-711
- ↑ Kinoshita T, Medof ME, Nussenzweig V, Endogenous association of decay-accelerating factor (DAF) with C4b and C3b on cell membranes, J Immunol, 1986;136:3390-3395
- ↑ Wiedmer T, Hall SE, Ortel TL, Kane WH, Rosse WF, Sims PJ, Complement-induced vesiculation and exposure of membrane prothrombinase sites in platelets of paroxysmal nocturnal hemoglobinuria, Blood, 1993;82:1192-1196
- ↑ Crosby WH, Paroxysmal nocturnal hemoglobinuria; a classic description by Paul Strübling in 1882, and a bibliography of the disease, Blood, 1951;6:270-284
- ↑ Hill A, DeZern AE, Kinoshita T, Brodsky RA, Paroxysmal nocturnal haemoglobinuria, Nat Rev Dis Primers, 2017;3:17028-17028
- 1 2 3 Devalet B, Mullier F, Chatelain B, Dogné JM, Chatelain C, Pathophysiology, diagnosis, and treatment of paroxysmal nocturnal hemoglobinuria: a review, Eur J Haematol, 2015;95:190-198
- ↑ (Dunn D.E. et al. Paroxysmal nocturnal hemoglobinuria cells in patients with bone marrow failure syndrome. Ann Intern Med 1999; 131 : 401 - 408)
- 1 2 Hillmen P, Lewis SM, Bessler M, Luzzatto L, Dacie JV, Natural history of paroxysmal nocturnal hemoglobinuria, N Engl J Med, 1995;333:1253-1258
- ↑ Fieni S, Bonfanti L, Gramellini D, Benassi L, Delsignore R, Clinical management of paroxysmal nocturnal hemoglobinuria in pregnancy: a case report and updated review, Obstet Gynecol Surv, 2006;61:593-601
- ↑ (en) Borowitz MJ, Craig FE, Digiuseppe JA et al. « Guidelines for the diagnosis and monitoring of paroxysmal nocturnal hemoglobinuria and related disorders by flow cytometry », Cytometry B Clin Cytom. 2010;78:211-230
- ↑ Peffault de Latour R, Schrezenmeier H, Bacigalupo A et al. Allogeneic stem cell transplantation in paroxysmal nocturnal hemoglobinuria, Haematologica, 2012;97:1666-1673
- ↑ Kelly RJ, Hill A, Arnold LM et al. Long-term treatment with eculizumab in paroxysmal nocturnal hemoglobinuria: sustained efficacy and improved survival, Blood, 2011;117:6786-6792
- ↑ Loschi M, Porcher R, Barraco F et al. Impact of eculizumab treatment on paroxysmal nocturnal hemoglobinuria: a treatment versus no-treatment study, Am J Hematol, 2016;91:366-370
- ↑ Hill A, Rother RP, Arnold L et al. Eculizumab prevents intravascular hemolysis in patients with paroxysmal nocturnal hemoglobinuria and unmasks low-level extravascular hemolysis occurring through C3 opsonization, Haematologica, 2010;95:567-573
- ↑ Kulasekararaj AG, Griffin M, Langemeijer S et al. Long-term safety and efficacy of ravulizumab in patients with paroxysmal nocturnal hemoglobinuria: 2-year results from two pivotal phase 3 studies, Eur J Haematol, 2022;109:205-214
- ↑ Hillmen P, Szer J, Weitz I et al. Pegcetacoplan versus eculizumab in paroxysmal nocturnal hemoglobinuria, N Eng J Med, 2021;384:1028-1037
- ↑ Peffault de Latour R, Röth A, Kulasekararaj AG et al. Oral iptacopan monotherapy in paroxysmal nocturnal hemoglobinuria, N Eng J Med, 2024;390:994-1008
Voir aussi
Articles connexes
- Glycosylphosphatidylinositol, GPI.
Liens externes
- Page spécifique sur Orphanet
- (en) 300818 : H.P.N. OMIM.
- (en) 311770 : gène PIGA, OMIM.
- Portail de la médecine
- Portail de l’hématologie